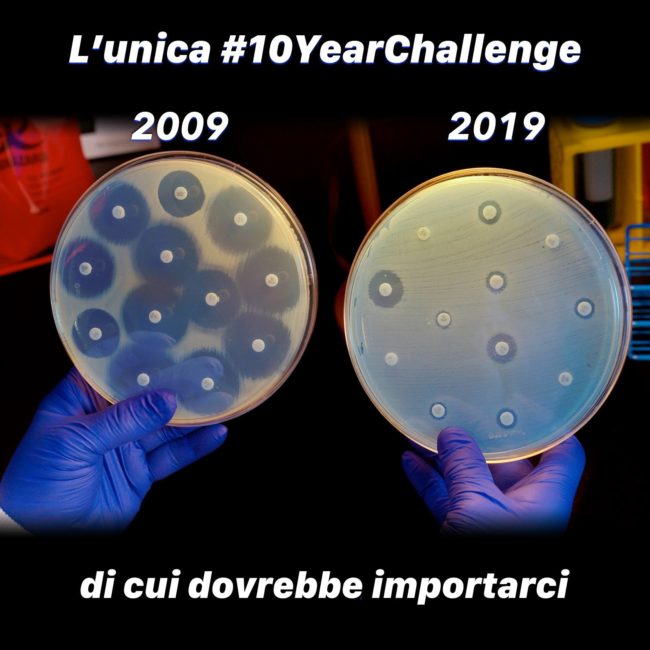
52851997_10215846274642225_5665230531084681216_o

LE CADUTE NEGLI ANZIANI: POSSIAMO PREVENIRLE?
Secondo una recente revisione sistematica, pubblicata dalla Cochrane risulta che la miglior strategia disponibile per contenere il rischio di cadute sia la prevenzione. Dobbiamo pensare che circa il 25% degli anziani >70 anni è vittima di cadute almeno una volta all’anno (50% per i > 80 anni). Non è un dato “isolato” perchè dobbiamo pensare…